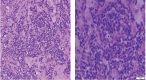

An unusual presentation of adult T-cell leukemia/lymphoma
- PMID: 29456618
- PMCID: PMC5813913
- DOI: 10.3332/ecancer.2018.801
An unusual presentation of adult T-cell leukemia/lymphoma
Abstract
Adult T-cell Leukemia/Lymphoma (ATL) is a rare disease, related to human T-lymphotropic virus-1 (HTLV-1) and presented mainly in adulthood by generalised lymphadenopathy, hepatosplenomegaly, skin lesions and hypercalcaemia, with rare gastrointestinal and/or oral manifestations. We reported this case to raise awareness and demonstrate the therapeutic challenges of this rare disease. A 49-year-old Japanese female presented with skin papules on both forearms, painful mouth ulcers and multiple neck swellings since early February 2017. Initial clinical examination and laboratory investigations were misleading and her condition was diagnosed as candidiasis. Because of un-improvement of the case, a screening upper endoscopy was requested 2 months later and revealed characteristic oropharyngeal ulcers which were biopsied, and its pathologic examination confirmed smouldering type ATL. This case report should raise awareness of doctors and endoscopists about this disease especially in HTLV-1 endemic areas to avoid late diagnosis and help achieve earlier therapeutic decisions.
Keywords: adult T-Cell leukaemia/lymphoma; endoscopic findings; human T-lymphotropic virus; lymphoma; oral ulcers; oropharyngeal ulcers.
Figures

References
Publication types
LinkOut - more resources
Full Text Sources
Other Literature Sources
